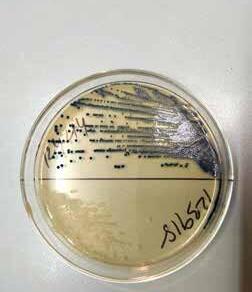

Från tandvårdsrädsla

till att förebygga parodontit
Kajsa Henning Abrahamsson är ny professor i oral hälsovetenskap.

SID 10–11

Här minskar
både stressen och patientköerna.
SID 6–8





Från tandvårdsrädsla

till att förebygga parodontit
Kajsa Henning Abrahamsson är ny professor i oral hälsovetenskap.

SID 10–11

Här minskar
både stressen och patientköerna.
SID 6–8




Hur kan tandvården minska stress och press i arbetsdagen och samtidigt korta patientköerna? I denna utgåva av TandhygienistTidningen kan du läsa om hur Folktandvården Örebro försöker lösa detta i ett pågående projekt. Patienten kan välja att boka sig enligt den nya modellen att bli färdigbehandlad under ett besök. De dagarna ställs rutinerna på kliniken om helt. Så kallade Dirigenter följer behandlingarna och justerar sluttiden efter hand som behandlingarna fortlöper. Ett helt team omsluter patienten som kan få träffa flera olika behandlare vid samma besök. Stressen har minskat, liksom patientköerna.
sid 14–15
Fler barn misstänks fara illa Socialstyrelsen lovar stärka kunskapsstödet till tandvården.
sid 16–19
Ny bok om tandvårdsrädsla En av fem vuxna i Sverige är drabbade.

En långsiktigt hållbar tandvård är även fokus för STHF:s TandhygienistDagar 2023 med temat ”Hållbar munhälsa – hållbar tandhygienist”. Där kommer deltagarna få lära sig det senaste inom parodontologi, nyttan med kvalitetsregistret SKaPa och ta del av diskussionen kring varför många patienter med parodontit inte blir friska trots omfattande behandling.
På TandhygienistDagarna 2023 i Karlstad kommer deltagarna även få del av en aktuell rapport om individens och samhällets behov av ett långt och hållbart arbetsliv, samt få tips om vad man själv kan göra för att hålla sig stark och glad både på arbetet och fritiden samt hur en skapar motivation och arbetsglädje på riktigt.
Trevlig läsning!
UTG IVA RE
Sveriges Tandhygienistförening
Box 1419, 111 84 STOCKHOLM.
Besöksadress: Oxtorgsgatan 9–11. 08-442 44 60. info@tandhygienistforening.se www.tandhygienistforening.se

UPPLAGA
3 500 ex. ISSN 1102-6146
NÄSTA UTGIVNING
14 april.
PRENUMERERA
Årsprenumerera på tryckt tidning! Beställ via e-post: info@tandhygienistforening.se. Priser inklusive porto. Företag i Sverige: 525 kr. Företag inom
Norden: 735 kr. Icke medlem och företag utanför
Norden: 1 260 kr.
CHEFREDAKTÖR OCH
PRODUKTIONSANSVARIG
Lena Munck, 070-971 84 91 redaktion@tandhygienistforening.se


ANSVARIG UTGIVARE
Yvonne Nyblom yvonne.nyblom@tandhygienistforening.se

ANNONSER, MATERIAL
OCH BOKNING
Christer Johansson, 070-574 55 82 annons@tandhygienistforening.se
TIDNINGSLAYOUT
Stina Oldmark layout@tandhygienistforening.se
TRYCK Trycks av Ljungbergs Tryckeri AB på G-Print från Grycksbo pappersbruk.
SVANENMÄRKET
Trycksak 3041 0116
STHF – EN DEL AV SRAT Sveriges Tandhygienistförening (STHF), är en förening inom SRAT, fackförbundet för akademiker inom hälsa, kommunikation och förvaltning. SRAT är ett av 22 medlemsförbund inom Saco.

– Vi vet att både munhälsa och livsstil är viktiga faktorer som har betydelse för flera av de icke-smittsamma sjukdomarna (NCD), liksom för karies och parodontit.
sthf är engagerad i det svenska NCD-nätverket, en sammanslutning av 25 civilsamhälleorganisationer som gemensamt, men på olika sätt, vill och kan påverka de samband som orsakar de icke smittsamma sjukdomarna. De sjukdomar som utgör majoriteten av förtida dödsfall i världen. Här i Sverige står NCD-sjukdomarna för 90 procent av alla dödsfall. Den högsta dödligheten står hjärt-kärlsjukdomar, cancer, diabetes och kroniska lungsjukdomar för. Vi vet att både munhälsa och livsstil är viktiga faktorer som har betydelse för flera av dessa sjukdomar, liksom för karies och parodontit. NCD-nätverkets övergripande mål är att öka antalet friska levnadsår, minska ojämlikhet i hälsan, främja åtgärder för bättre hälsa och stärka befolkningens tillgång till hälso- och sjukvård, och inte minst prevention.
i början av året presenterade WHO en deklaration om förebyggande åtgärder för att hålla nere förekomsten av NCD, Non Communicable Diseases, en global handlingsplan för munhälsa 2023–2030. Under flera år har arbetet pågått med att inkludera munhälsans betydelse
för allmänhälsa i ett universellt hälsoskydd. Nu presenteras en plan med åtgärder som har sin utgångspunkt i att munnens sjukdomar har en global förekomst på 45 procent, mer än någon annan NCD, och kostar globalt cirka 387 miljarder dollar årligen.
som tandhygienist blir jag särskilt glad att se att hälsofrämjande och förebyggande har stort fokus i planen. Jag konstaterar bland annat att de flesta orala sjukdomar och tillstånd kan förebyggas och åtgärdas effektivt genom befolkningsbaserade folkhälsoåtgärder på olika nivåer. Politiska insatser uppströms, som de som riktar sig till sociala och kommersiella bestämningsfaktorer, är kostnadseffektiva med hög befolkningsräckvidd och stor effekt. Midstream-initiativ kan inkludera skapandet av mer stödjande förhållanden i nyckelmiljöer som skolor, arbetsplatser och i omsorg en. Nedströmsinsatser är också avgörande, exempelvis förebyggande metoder och evidensbaserad klinisk munhälsovård.
who: s resolution uppmanar medlemsstaterna att utarbeta och omsätta den globala strategin till en handlingsplan för folkhäl-
MEDARBETARE I DETTA NUMMER / TIPSA OSS GÄRNA!
CHEFREDAKTÖR lena munck redaktion@tandhygienistforening.se







VETENSKAPLIG REDAKTÖR
katarina konradsson Universitetslektor Umeå Universitet katarina.a.konradsson@umu.se
SKRIBENT marie skoglund skoglundreportage@gmail.com
SKRIBENT lina gassner kanters linakanters@gmail.com
san, inklusive ett ramverk för att mäta framsteg som ska uppnås fram till 2030. Åtgärder som att utveckla teknisk vägledning för miljövänlig och mindre invasiv tandvård och att fortsätta uppdatera teknisk vägledning för att säkerställa säkra och kontinuerliga tandvårdstjänster. WHO lyfter även behovet av att se över vilken typ av personal som gemensamt ska kunna bidra till att varje land kan erbjuda en god tandvård till befolkningen. Något som vi även efterfrågar i Sverige.
I alla dessa led kan och ska vi arbeta med att utveckla och stärka munhälsan här i vårt land. Vi har redan kommit väldigt långt i jämförelse med många andra och kan bidra med erfarenheter och kunskap. NCD-nätverket är en plattform för att sprida den vidare.
SKRIBENT camilla adolfsson camilla.adolfsson@pratminus.se
SKRIBENT magnus trogen pahlén magnus@provins.se
SKRIBENT fredrik mårtensson fr.martensson@gmail.com

TIDNINGSLAYOUT stina oldmark layout@tandhygienistforening.se
ANNONSANSVARIG christer johansson annons@tandhygienistforening.se



KORREKTUR marinette ask shantibalans@gmail.com
2508 följer oss på Facebook. 1063 följer oss på Instagram. #sverigestandhygienister
ProphyCare® HAp innehåller hydroxylapatit som bidrar till att lindra besvär från ilande tandhalsar. Läs mer om ProphyCare HAp genom att skanna QR koden

Ett nytt arbetssätt kan minska personalens stress, ge en mer varierad arbetsdag och innebära färre återbesök för patienterna. Nu sprider Folktandvården Direkt metoden till fler tandvårdskliniker i Region Örebro.
– En vinst
både för oss
och patienten är att undvika återbesök.

initiativet till regionens nya arbetssätt, som fått namnet Folktandvården Direkt, kommer från
hos medarbetarna och även en mycket begränsad tillgänglighet för patienterna. Så med start
Modellen har som mål att i så hög grad som möjligt färdigbehandla patienterna redan vid första besöket och bygger bland annat på flexibla start- och sluttider för besöken (se faktaruta).
Slutrapporten från Lindesberg visar också att fler av patienterna färdigbehandlats på kortare tid än tidigare och att kötiden för vuxna minskat från cirka två år till cirka tre månader.
Sedan i höstas har arbetssättet även införts vid Folktandvårdens klinik Eyra i Örebro. Här arbetar Linda Edner, tandhygienist och enhetskoordinator, sedan starten av kliniken 2017. Eyra-kliniken har i dag cirka 18 000 patienter, varav ungefär 8000 är barn. Kliniken ligger nära Örebro universitetet, vilket gör att många studenter söker sig hit för tandvård. Sedan en tid har kliniken tvingats neka nya patienter.

– Detta var en av anledningarna till att vi ville prova arbetsmetoden Folktandvården Direkt, tillsammans med möjligheten att skapa en bättre arbetsmiljö, säger Linda Edner.
Minskad stress
Hittills har testperioden pågått enbart några månader, men flera vinster har redan blivit tydliga.
– En vinst både för oss och för patienten är att undvika återbesök. Men för oss är det också en arbetsmiljöfråga där arbetssättet minskar stressen hos personalen. Nu kan vi ta den tid som behövs för varje patient utan att anpassa oss till en sluttid.
Arbetsmetoden skiljer sig rejält från den traditionella där tidboken styr varje arbetsdag. Här planeras insatserna först när patienten satt sig till rätta i stolen.
– Vi tvingas tänka lite tvärtom än tidigare. Vi är ju vana vid att alltid arbeta med en sluttid i sikte, men här sätter vi den inte förrän vi lyssnat till patientens
Folktandvården Direkt har nu spridit sig till klinikerna Eyra och Hertig Karl i Örebro.
Sluttiden för behandlingen kan även ändras under en pågående behandling, berättar hon.
För att det ska kunna fungera för alla på kliniken arbetar vissa av dem i en planerande roll. Deras uppgift är att hålla en aktiv kommunikation med varje behandlare och anpassa allas arbetsuppgifter efter pågående behandlingar.
Den planerande rollen har fått namnet Dirigent, och under de dagar i veckan som kliniken arbetar enligt arbetssättet, styr tre Dirigenter över arbetet.
– Under dessa dagar är behandlingstiderna flytande. Hittills har den längsta behandlingen hållit på i cirka tre timmar.
Aktiv patientdialog
Ett exempel kan vara att tandläkaren hittar ett hål i en tand vid en undersökning och frågar patienten om de ska åtgärda det direkt. Patienten tycker det är en bra idé, men när behandlingen påbörjas så upptäcks sprickor i tanden. Tandläkaren beslutar då i samråd med patienten att i stället ta bort tanden. Samtidigt kommunicerar tandläkaren med Dirigenten inför varje förändring för att den ska passa med resten av kliniken.
– Vi står alla beredda att rycka in där det behövs. Även som tandhygienist blir arbetsdagen mycket mer omväxlande och du får möjlighet att arbeta tillsammans med fler kollegor vid kliniken än tidigare, säger Linda Edner.
Fortfarande är det för tidigt att utvärdera försöket fullt ut, menar hon. Dessutom justerar de fortfarande ramarna för arbetsmetoden för att hitta rätt.
– Det handlar framför allt om att hitta en balans av antal patienter per dag för att hinna behandla alla samt kunna anpassa det efter eventuell frånvaro och även efter jourpatienter.
Nu erbjuder kliniken alla patienter Folktandvården Direkt som förstahandsval för behandlingen, men tre dagar i veckan följer arbetet fortfarande den traditionella arbetsmodellen.
– Vi vill ta ett steg i taget helt enkelt. Än så länge är det bara vuxna patienter vi behandlar med den nya metoden, barnen får en traditionell behandling.
Metoden innebär även ett nytt förhållningssätt för patienterna. Vissa har upplevt det utmanande att inte få en exakt starttid för sin behandling.
– Det kan upplevas svårt för vissa, till exempel äldre patienter. Att dessutom inte veta vilken behandlare man möter kan vara svårt för mycket tandvårdsrädda patienter. Därför kan alla patienter välja metod även i fortsättningen, säger Linda Edner.
Bland fördelarna för patienterna finns att slippa upprepade besök med frånvaro från sina arbeten samt möjligheten att själva bidra i behandlingarna i större utsträckning än tidigare.
– Patienterna har mött försöket mycket positivt. De är vana vid mycket korta besök, men här får de mer tid och kan få det de vill ha åtgärdat gjort med en gång.
För kliniken har de mer koncentrerade behandlingarna inneburit en mindre åtgång av engångsmaterial och mindre disk än tidigare. Något som också visade sig under försöket i Lindesberg, vilket bidrog till att den kliniken fick Region Örebro läns Miljöpris 2022.
De flytande arbetsuppgifterna för personalen har även gjort att vissa luckor uppstått under dagen.
Arbetssättet Folktandvården Direkt erbjuder patienten en möjlighet att styra sin behandling till ett och samma besök. Här finns ingen traditionell start- och sluttid, utan en kommer överens med sin behandlare på plats vad som ska utföras under besöket.
Vid bokningen väljer patienten inom vilken timme besöket ska börja, till exempel mellan klockan 14.00 och 15.00. Cirka 30 minuter innan besöket får patienten ett sms med den exakta starttiden, till exempel klockan 14.20. Sedan kan behandlingen och tiden anpassas under besöket utan att det finns en definitiv sluttid.

Patienterna kan även välja att boka tid via 1177.se och Region Örebro läns webbplats, eller ringa till klinikerna. Folktandvården Direkt bygger på en driftsmodell utvecklad i Helsingfors i Finland. Där startades en helt ny tandvårdsklinik 2010 med målsättning att utveckla en ny verksamhetsmodell för hela hälso- och sjukvården. Modellen har sedan spridit sig i grannlandet och först ut att testa den i Sverige var Folktandvården i Region Norrbotten. Metoden kallas Hygga Flow och marknadsförs nu även i andra europeiska länder som en flödesoptimerad verksamhetsstyrning.
– Ibland blir det lite pauser mellan olika patienter och det kan vissa uppleva lite oroande då de är vana att hela tiden gå från patient till patient. Men vi försöker påminna om att det är bra med lite pauser ibland, säger Linda Edner.
Det handlar framför allt om att hitta en balans av antal patienter per dag för att hinna behandla alla.Linda Edner
Mjuka gummiborst med MINTSMAK








Flexibel och böjbar hals



Ergonomiskt grepp








Finns i SMALL, MEDIUM & LARGE

Sedan Kajsa Henning Abrahamsson utbildade sig till tandhygienist för fyrtio

år sedan har utbildningen genomgått stor förändring: från en kort yrkesutbildning för tandsköterskor till en akademisk kandidatexamen. Nu är hon den första tandhygienisten att bli professor vid Göteborgs universitet.
kajsa har odontologen i Göteborg som sin arbetsplats sedan över tjugofem år. Hon har under sin långa karriär på flera sätt varit en föregångare. År 2003 blev hon en av de första tandhygienisterna att disputera i Sverige, och nu blir hon den fjärde professorn i landet med den bakgrunden, och den första vid Göteborgs universitet.
– Många tandhygienister kanske inte tänker på de möjligheter som finns och där har vi som varit pionjärer kunnat bana vägen. En professur i oral hälsovetenskap
STHF-FAKTA OM KAJSA
HENNING ABRAHAMSSON:
Ledamot i Sveriges
Tandhygienistförenings
styrelse 1995–2001
International director
Sveriges Tandhygienistförening 2001–2013
Ledamot/ordförande
i STHF:s vetenskapliga
råd 2003–2023
stärker ämnets utveckling här på universitetet. För våra studenter tror jag att det betyder mycket att de professorer de möter inte bara är tandläkare, säger Kajsa på universitets hemsida.
Hon konstaterar att ämnet oral hälsa är akademiskt välförankrat på universitetet. Två av Kajsas kollegor är docenter och tandhygienistprogrammet har ett flertal disputerade lärare som själva är tandhygienister.
– Totalt har bara 44 tandhygienister i hela landet disputerat,
och flera av dem är knutna till Göteborgs universitet. Vi är en grupp kollegor som driver mycket forskning gemensamt och som stöttar och hjälper varandra.
En lång resa
Hennes egen karriär har drivits av en vilja att hela tiden utvecklas. Hon insåg att hon trivdes i tandvården när hon som ung fick praktik som tandsköterska. Yrkesutbildningen till tandhygienist var då en ettårig påbyggnad för tandsköterskor. Kajsa tog sin tandhygienistexamen 1982, i en av de första studentkullarna i Göteborg.
– Det var ett roligt och självständigt jobb, men jag upplevde snart att jag befann mig i något av en återvändsgränd. Jag var intresserad av att fortsätta fördjupa mig och ville gå vidare, berättar Kajsa.
Hon kombinerade jobbet som tandhygienist med halvtidsstudier på psykologen och fick ut en magisterexamen i psykologi. Hennes tanke var att sadla om till att arbeta med ledarskap och arbetsorganisation, men slumpen förde henne tillbaka till tandvården:
– Jag genomförde ett examensarbete kring fobisk tandvårdsrädsla, vilket så småningom resulterade i min avhandling med samma ämne, med Ulf Berggren som handledare, berättar Kajsa.
Från tandvårdsrädsla till att förebygga parodontit Efter disputationen 2003 befordrades hon från adjunkt till universitetslektor, med nytt forskningsfokus mot förebyggande och behandling av parodontala sjukdomar, både bland unga och vuxna.
Trots all den tandvård som barn och ungdomar får är munhygienen generellt dålig i stora grupper av unga och kunskapen om vad inflammation i tandköttet leder till är skral. Att arbeta för beteendeförändringar och inspirera patienter att upprätthålla den munhygien som krävs är en
viktig del av tandhygienisters arbete. Men hur borde den informationen ges?
Intervention för förbättrad munhygien bland ungdomar I en studie, genomförd av doktoranden Sandra Lod Dimenäs, får ungdomar testa en intervention för förbättrad munhygien som tidigare visat sig ge resultat på vuxna. Interventionen är baserad på hälsopsykologiska teorier, där tandhygienisten även har tränats i att använda personcentrerad kommunikation i dialogen med ungdomarna.
– Förutom kunskap behöver individen också tycka att det finns en fördel med att förändra sitt beteende. Det måste finnas målsättningar, inte bara på lång sikt utan också på kort sikt. Interventionen innebär bland annat att tandhygienisten för ett motiverande samtal med patienten där de diskuterar det individuella målet för personens hälsa och hälsobeteende, och även rent praktiskt vilket stöd som personen kan få i sin omgivning för att upprätthålla det önskade beteendet, berättar Kajsa.
Strax över 300 ungdomar har antingen fått den teoribaserade interventionen, eller konventionell information från sin tandhygienist. Uppföljning sex månader efter besöken visar att den teoribaserade interventionen är mer effektiv än konventionell information. Nu går forskargruppen vidare och ser hur resultaten står sig över tid och med målsättning att kunna utveckla mer effektiva metoder för att påverka unga patienter till ett beteende som gynnar deras orala hälsa.
Behandling av parodontit hos vuxna Parodontitbehandlingen inleds ofta med att tandhygienisten avlägsnar de bakterieplack som bildats i fickorna med handinstrument eller med ultraljud, eller en kombination av dessa metoder. Denna behandling ges vanligtvis fördelat på flera behandlingsbesök. Tandhy-
gienisten kan också välja att bara använda ultraljud vid ett och samma tillfälle i syfte att undvika överbehandling, något som brukar kallas full-mouth.
Kajsa H Abrahamsson berättar om en stor fältstudie som hon och hennes kollegor just genomfört, där de jämfört hur bra dessa behandlingsmetoder fungerar i den kliniska vardagen. Det är en randomiserad studie som involverat 700 patienter och 90 tandhygienister inom Folktandvården i Västra Götalandsregionen, och som startades på initiativ av professor Jan Wennström innan han avled 2021.
I tidigare randomiserade och kontrollerade studier, ofta genomförda på specialistkliniker, har båda metoderna visats ge likvärdiga resultat vad gäller kliniskt utfall.
– Det unika med vår studie är att vi nu har visat att metoderna ger samma resultat när behandlingen genomförs i den kliniska vardagen, säger Kajsa.
Även om båda metoderna fungerar lika bra så finns det tidsmässiga fördelar med att genomföra den initiala behandlingen med ultraljud vid ett tillfälle. Kajsa H. Abrahamsson poängterar att oavsett vilken metod man väljer för sin instrumentering så är förstås patientens egenvård även här helt avgörande för ett lyckat behandlingsresultat.
– Det vi också visade i den här studien var att patientens känsla av delaktighet i behandlingen var en viktig faktor för behandlingsresultatet.
en tidigare doktorand, Anna Liss, har nyligen disputerat inom denna fältstudie. Nu genomför forskarna bakom studien en 18-månadersuppföljning och går även vidare med studier, baserade på det mycket omfattande SKAPA-registret, där de bland annat undersöker hur behandlingen fortsatt och om patienter med parodontit får vård på lika villkor.

Tandkräm som innehåller NovaMin är kliniskt bevisad att den hjälper till att skydda mot ilningar genom att bilda ett robust reparativt lager över områden med exponerat dentin1,2,3


Kliniskt bevisad för långvarigt skydd** mot dentinöverkänslighet
Bildar ett reparerande lager*
över det exponerade dentinet
Hjälper till att skydda mot ilningar i tänderna genom att lindra ilningar, stärka emaljen och hjälpa till att hålla tandköttet friskt** Nr.1
TANDKRÄM SOM REKOMMENDERAS AV TANDLÄKARE FÖR ILNINGAR I TÄNDERNA4
1. Greenspan DC et al. J Clin Dent 2010; 21: 61-65. 11. La Torre G and Greenspan DC. J Clin Dent 9. 2010; 21(Spec Iss): 72-76. 2. Earl JS et al. J Clin Dent 2011; 22(3): 62-67(A). 3. Parkinson et al. J Clin Dent 2011; 22(3): 74-81. 4. © Ipsos | Claim Test in Sweden 2022den nätta lilla damen med sina 73 somrar har just passerat mina händer i sin årliga undersökning. Hon är lätt i kroppen, frisk i mun och har solsken i blick. Vi är färdiga, haklappen är borta, hon sitter kvar sådär lite på tvären i stolen.
– Joo… jag har en fundering… är det dags för mig att gå över till implantat nu kanske? Jag tappar hakan lite lätt bakom mitt munskydd… sitter tyst och väntar.
– Jaaa jo alla mina kompisar håller på nu med de där implantaten. Och då… ja så då tänkte jag att det är nog bäst ändå att fråga… vad tycker du?
ja vad tycker jag? Vad tycker tandvården? Den svenska tandvården drar ut tänder nu, det finns en stark tro på implantaten. Det skruvas som aldrig förr på klinikerna. Endodonti är inget för oss – skruva, skruva, skruva in ditt glada flin – sjöng hon Gullan Bornemark. Det kliar i fingrarna på tandläkarna och kittlar dödsskönt i kistan. Skruvar kostar. Cash. Implantiten som vi hörde om på riksstämman i år slår alla rekord. Lossar tänderna av parodontit så lossar skruvarna av implantit. Tandlossning blir skruvlossning. Det är tio gånger högre risk att förlora en skruv om tandförlusten beror på parodontit. Biologin är viktigare än tekniken. Munhygien och en bra tandhygienist är lösningen. Man kan inte skruva sig lycklig. Det finns inga genvägar till det perfekta bettet. Skruven är lös. Undrar på vem?

så vad svarar jag den lilla damen? – Du har fina friska tänder och ett vackert leende att vara stolt över. Du behöver inga skruvar för du har fattat hur det funkar.
KARIN SJÖGREN Leg tandläkare, Odont dr, Affärskommunikatör karinsjogren@telia.comOrosanmälningarna har ökat med 27 procent sedan 2018, visar en kartläggning gjord av Socialstyrelsen. Nu vill myndigheten se mer detaljerade anmälningar och ökad uppmärksamhet på omsorgsbrister som kan drabba yngre barn.
nu vill myndigheten se mer detaljerade anmälningar och ökad uppmärksamhet på omsorgsbrister som kan drabba yngre barn.
– Kartläggningen visar ett behov av att öka kunskapen om anmälningsskyldighet – i synnerhet när det gäller olika former av omsorgsbrister. Där behöver tandvården, liksom andra aktörer som möter yngre barn, bli bättre, säger Therese Olmsäter, ansvarig utredare på Socialstyrelsen för den andra, nationella kartläggningen om de orosanmälningar som kommunernas socialtjänster tar emot.
kartläggningen gäller för 2021 och totalt gjordes då 422 000 anmälningar, en ökning med 27 procent jämfört med 2018. Var tionde barn berördes av en orosanmälan.
I rapporten »Anmälningar om barn som far illa eller misstänks fara illa 2021« lyfter Socialstyrelsen ökad anmälningsbenägenhet som grundorsak till ökningen av orosanmälningar.
Det gäller exempelvis ökad uppmärksamhet sedan Barnkonventionen blivit lag och att det blivit enklare att anmäla genom digitala e-tjänster.
Men trots ökningen ser Socialstyrelsen en underrapportering och bedömer att det särskilt gäller föräldrars bristande omsorgsförmåga för de yngsta barnen.
– Små barn har inte lika mycket kontakter med andra vuxna som äldre barn kan ha, samtidigt som tandvården är en av de aktörer som träffar så gott som alla barn, oavsett ålder. Därför är det viktigt att tandvården har särskild uppmärksamhet på tecken på omsorgsbrister bland små barn, säger Therese Olmsäter.
– Det vi får beskrivet för oss är att tandvården inte alltid gör anmälningar, trots att man känner oro eller ser omsorgsbrister. Man kopplar inte alltid tecken på omsorgsbrister till att göra en orosanmälan eller misstanke om föräldrars bristande omsorgsförmåga. Så utifrån det kan vi se att tandvården behöver stärka kunskaperna och i högre grad anmäla både tecken på omsorgsbrister och olika former av våldsutsatthet.
therese olmsäter har förståelse för den osäkerhet som kan finnas kring orosanmälningar och betonar behovet om ökad, generell kunskap.

– En bra linje är att skriva det man känner till som behandlare. Informationen man har kan vara luddig men då får man försöka formulera det. Men om det är så att det finns mer information om barnet, familjen eller att man ser tydliga tecken på omsorgsbrister – då är det viktig information att ha med i sin orosanmälan.
– Även historik man har från tidigare möte med barnet kan vara viktig – det är absolut delar som man ska ta med i beskrivningen. Sedan finns alltid möjligheten att ringa och konsultera socialtjänsten om man är osäker eller behöver stöd om man står inför en situation där man misstänker eller har kännedom om att ett barn far illa.
Från tandvården kan uteblivna besök vara en grund för orosanmälningar. Men Socialstyrelsen ser ett problem med att de ofta lämnas in »i klump«.
– Att alla anmälningar som rör uteblivna besök exempelvis kommer vid ett tillfälle under året. I vissa fall finns det heller inte någon mer information än att det rubriceras som ett uteblivet besök. Det gör det svårt för socialtjänsten att bedöma oron för barnet, säger Therese Olmsäter.
vården – där hälso-, sjuk- och tandvård räknas som enhet – är jämte polis och skola de största anmälarna. Tillsammans stod de för ungefär 60 procent av anmälningarna under 2021.
folktandvården Sörmland och Folktandvården Uppsala är två tandvårdsorganisationer som sett en stadig ökning av orosanmälningar.
I Folktandvården Sörmland var ökningen 13 procent förra året. För några år sedan gjordes en större genomgång av anmälningar som grund för att förbättra arbetet.
– Rutinerna kring orosanmälningar har egentligen funnits länge, men sedan 2021 har vi dem samlade i en särskild handlingsplan för att förenkla arbetet. I handlingsplanen finns avsnitt om olika situationer där vi kan känna oro för en barnpatient och rutiner för att hantera dessa, säger Kajsa Palmblad, tandhygienist med en tjänst som vårdutvecklare och barnrättsansvarig inom Folktandvården Sörmland.
fördjupat samarbete med socialtjänsten har bidragit till kunskap för att formulera anmälningar av hög kvalitet.
– Fokus ska vara att skriva utifrån oron och riskerna vi ser som exempelvis framtida infektioner eller smärta. En annan viktig del är att få med historiken, om vi exempelvis orosanmält tidigare, för att ge socialtjänsten ett bra underlag.
– Vi har även rutiner för att rådgöra med socialtjänsten om det finns frågor kring en orosanmälan. Flera kliniker har också bjudit in socialtjänsten i sin kommun till informationsträffar, säger Kajsa Palmblad.
hon håller med om att delar av arbetet kan vara komplicerat.
– En svårighet som personalen vittnar om är när barn kommer till undersökning, men där vi kan se att man inte följer rekommendationer. Att vi inte ser att det blir
en beteendeförändring kring levnadsvanor, trots att det kan låta positivt från föräldrarna när vi möter dem.
I det läget har vi satt in de resurser som vi har och kan ha svårt att förhålla oss till hur vi bör gå vidare, exempelvis om en orosanmälan kring försummelse skulle vara lämplig.
– Uteblivna besök är på sätt och vis enklare att hantera och där har vi mallar för orosbrev som vi skickar ut till föräldrarna. Den delen fungerar väldigt bra och i de allra flesta fall hör föräldrarna av sig efter att ha fått ett brev och vi kan hitta en ny tid för barnet, säger Kajsa Palmblad.
folktandvården Uppsala uppdaterade sina rutiner 2020 och det gav direkt en stor ökning av orosanmälningar, från 55 anmälningar 2020 till 193 under 2021.
– Rutinerna för när ett barn uteblir från en undersökning eller behandling tydliggjordes och sedan dess journalförs orosanmälningarna i journalsys -
temet med en specifik kod, något som inte gjordes förut. Genom att rutinerna har blivit tydligare och även enklare så tror jag att medarbetare känner sig tryggare och säkrare när en orosanmälan görs, säger Kristin Markman, tandhygienist och munhälsosamordnare inom Folktandvården Uppsala.


Hon ser ett utrymme för att stärka samarbetet ytterligare med socialtjänsten.
– Medarbetarna har efterfrågat återkoppling från socialtjänsten när en orosanmälan görs, något som vi kan önska men inte alltid får. Återkopplingen kan ge ett svar om hur kliniken ska fortsätta arbeta med patienten.
socialstyrelsen lovar att stärka kunskapsstödet till bland annat tandvården.
– Under 2022 uppdaterades Socialstyrelsens handbok för anmälningsskyldiga med bland annat ett nytt avsnitt om vad en anmälan bör innehålla. Ett arbete som pågår är att uppdatera vår handbok om våld i nära relationer och där kommer det att finnas ett avsnitt som specifikt rör tandvårdens arbete med att upptäcka omsorgsbrister och våldsutsatthet, säger Therese Olmsäter.
– Vi uppdaterar också kontinuerligt vår webbplats kunskapsguiden.se och där finns en hel del material för tandvården att hämta. Det finns också en vägledning om våld mot funktionsnedsatta barn med ett avsnitt om tandvårdens ansvar och arbete.
– Fokus ska vara att skriva utifrån oron och riskerna vi ser som exempelvis framtida infektioner eller smärta.
En av fem vuxna i Sverige är idag drabbade av tandvårdsrädsla vilket gör den nyutgivna boken Tandvårdsrädsla, angelägen för oss i tandvården. Tandhygienist Lina Kanters har läst boken och intervjuat två tandvårdsrädda patienter.

Vad kännetecknar en person med tandvårdsrädsla?
Vad specifikt är personen rädd för? Författarna Ulla Wide och Magnus Hakeberg uppmanar läsaren att reflektera över just de två frågorna. Ja, hur skulle du beskriva en person med tandvårdsrädsla? Det finns inget rätt eller fel här, men det är bra att ha med sig att tandvårdsrädsla inte är ett begrepp som ter sig precis likadant hos alla människor, utan är ett spann av faktorer och känslor som kommer till uttryck på flera olika sätt. Sanningen är att vi inte kan säga att en person är tandvårdsrädd utifrån vissa kriterier eller bara genom att titta på dem. Enligt författarna, som i många år behandlat patienter med svår tandvårdsrädsla, kommer individer med tandvårdsrädsla från alla sociala grupper, inkomstnivåer och yrken dock med en överrepresentation av människor med lägre socioekonomisk status och av kvinnor.
Boken är välskriven och språkbilden är saklig och professionell utan att bli stel. Efter en snabb genomgång av det befintliga bokutbudet om tandvårdsrädsla på svenska konstaterar jag att det är magert. Efter samtal med kliniskt verksamma tandhygienister
förstår jag att ämnet inte behandlats i större utsträckning under grundutbildningen. Boken Tandvårdsrädsla är inte bara trevlig och utvecklande att läsa – den fyller kanske också ett tomrum på bibliotek och i kurslitteraturlistor.
Hur vet vi då vilka patienter som har tandvårdsrädsla? Att inkludera en övergripande fråga i ett inledande samtal är bra. Men för att kunna anpassa behandlingen och ge ett empatiskt bemötande behöver vi också veta mer specifikt vad eller vilka situationer som väcker obehag eller rädsla hos patienten. Oavsett orsaken till rädslan så är positiv förstärkning som kommentaren ”Så bra att du är här idag!” att rekommendera. Boken ger dig som läsare flera värdefulla tips om lämpliga behandlingsstrategier och hur du på bästa sätt kan förstå, bemöta och hjälpa dina patienter. Författarna beskriver också Göteborgsmodellen som använts med stor framgång för patienter med svår tandvårdsrädsla och fobi. I början av boken tar författarna upp tandvårdsrädslans historik, epidemiologi och konsekvenser och det blir tydligt att tandvårdsrädsla är ett
folkhälsoproblem – en av fem vuxna i Sverige är drabbade. Större insikter i patienternas perspektiv hade varit intressant, men det går att skaffa sig själv genom att fråga en patient och naturligtvis lyssna aktivt.
Jämfört med för 50 år sedan besöker nu betydligt fler personer med svår tandvårdsrädsla tandvården regelbundet. Det är en positiv utveckling då fler människor nu får chansen till en god oral hälsa. Det ställer dock högre krav på tandvården att möta och hjälpa denna patientgrupp. Det är viktigt att tandhygienisten har god kunskap om att undvika och förebygga tandvårdsrädsla. Författarna skriver i inledningen att de önskar att boken ska vara till praktisk nytta och det målet bör uppnås med lätthet. Att läsa boken Tandvårdsrädsla och att applicera din nya kunskap i din kliniska vardag kan ta dig en lång väg mot att hjälpa fler människor till en bättre munhälsa och ökad livskvalitet.
På följande sidor kan du läsa två patientfall som kopplar an till boken.
TEXT: LINA KANTERS
Visa era patienter att ni arbetar med produkter i biobaserad fossilfri Grön PE För en hållbar framtid
By using consumables in fossil-free Green PE made from renewable recourses,


Tandläkarna AB
_______________________________
contributes to reducing the level of carbon dioxide in the atmosphere for a sustainable future.
Beställ ert certifikat på www.orsing.se

julia är en välutbildad kvinna, 35 år gammal, med en mild form av tandvårdsrädsla. Hon vet inte varför hon känner obehag vid tandvårsbesök, det har aldrig hänt något traumatiskt. Hon var 10–12 år när tandvårdsbesök började kännas som någonting otäckt. Hon gick regelbundet till tandvården som barn men slutade när hon blev myndig och hade ett uppehåll på cirka 10 år. På grund av besvär i käkleden uppsökte hon vårdcentralen som rekommenderade henne att uppsöka tandläkare och de senaste åren har hon återigen gått regelbundet.
anledningen till tandvårdsrädslan är oklar – hon har aldrig gjort några stora ingrepp och hennes föräldrar är inte tandvårdsrädda. Tandläkaren som hela familjen gick till när Julia var barn upplevde hon dock som lite stressad, »hattig och flängig«, och han pratade mycket. När Julia funderar på vad det är hon inte gillar i tandvården så kommer hon fram till att det är väldigt många »upplevelser« samtidigt. Man känner och hör vad som görs, det smakar och luktar, men samtidigt ser man inte vad som händer. Dessutom är det i munnen, en viktig del av kroppen som man ska andas och prata med.
faktorer som påverkar positivt är när det är lugnt, när tand-
vårdspersonalen berättar vad de gör, men inte pratar för mycket i övrigt.
julia går varje gång kallelsen kommer, eftersom hon vill ha bra tänder och vet att det är viktigt med god munhälsa. Hon skulle trots detta hellre bryta benet än få hål i en tand.
enligt boken Tandvårdsrädsla kan det absolut vara så att man inte vet varför man har en stark rädsla. Forskning har visat att människor kan »lära in« en rädsla, något som kallas associationsinlärning eller klassisk betingning. Vi tycks ha en större benägenhet att utveckla rädslor för vissa typer av situationer och objekt, som till exempel för ormar och trånga utrymmen.


 TEXT: LINA KANTERS FOTO: MATILDA HOLMBERG
TEXT: LINA KANTERS FOTO: MATILDA HOLMBERG
maja är 43 år, har två universitetsexamina, är en fena på att sy och driver ett kreativt företag bredvid sitt vanliga arbete på ett bygg- och anläggningsföretag. Maja är, som hon själv säger, livrädd för att gå till tandvården.

Hennes rädsla bygger på en cykelolycka när hon var 5 år gammal. Stänkskärmen, på den tiden av metall, gick in via hakan och ut i omslagsvecket i underkäken. Såret syddes men man tittade inte så noga på tänderna. Maja hade dock jätteont och efter ett par veckor upptäcktes att flera tänder i båda käkarna var förstörda och arbetet med att ta ut dem påbörjades. Detta blev ett stort trauma för Maja, som hölls fast av tandsköterskor och sin äldre syster när tandläkare Sune i Folktandvården tog bort trasiga kronor och extraherade rötter.
maja gick till tandläkaren under uppväxten för att hon var tvungen, men slutade gå när hon flyttade hemifrån vid 16 års ålder. En gång under tonåren fick hon extrahera en premolar, men det gjordes under sedering.
Maja undvek tandvården fram tills hon blev 25. Då fick hon sitt första riktiga jobb och hade en chef som tyckte det var hemskt att hon var så tandvårdsrädd. Chefen ringde sin svägerska, som var tandläkare, och bad henne hjälpa Maja. Maja gick dit vid flera tillfällen – till en början med att bara sitta i stolen, sedan gapa och till slut kunde en hel undersökning och lite scaling genomföras. Maja fick förslaget att extrahera en mesialtippad
visdomstand, men hon vägrade. Hon har de senaste 15 åren inte gått till tandvården alls.
maja har tur att de permanenta tänderna varit friska. Hon har aldrig haft hål eller bekymmer trots att hon inte tar hand om sina tänder så som hon vet att man »ska«. Hon känner inget behov av att gå till tandvården just för att hon inte har några problem. Hon tycker att hela upplevelsen är jobbig, får hjärtklappning och svettningar och är orolig för att hon ska få höra att något är fel och behöver åtgärdas.
maja känner att det finns ett socialt stigma kring tandvårdsrädsla, att folk inte förstår att man kan vara rädd. »Att öppna munnen, hur svårt kan det vara?« Hon upplever att hon mött den attityden bland vänner, men även i tandvården.

Det finns flera typer av risk- eller orsaksfaktorer till tandvårdsrädsla. De brukar delas upp i dentala, individuella/personliga och externa/sociala faktorer. I Majas fall är orsaken dålig erfarenhet av tandvården – framför allt hårdhänt och dåligt bemötande samt avsaknad av kontroll. Detta räknas som dentala faktorer. Tandläkaren som Maja gick
till när hon var 25 gjorde helt rätt i att Maja gradvis fick närma sig det som väcker rädsla. Allt ska ske i små steg med möjlighet att pausa och avbryta.
metoden stegvis behandlingsstrategi har mycket gemensamt med barntandvårdens »tell-showdo«. Forskning och författarnas kliniska erfarenhet visar att ett arbetssätt där man kombinerar ett gradvis närmande med avslappningstekniker är mycket effektivt för att på sikt minska tandvårdsrädsla.
TEXT: LINA KANTERS

personer som snusar löper högre risk att dö för tidigt än icke-snusare. Den högre dödligheten kan inte förklaras av socioekonomiska faktorer. Studien, som är den hittills största i sitt slag i världen, har utförts av Marja Lisa Byhamre vid Institutionen för folkhälsa och klinisk medicin vid Umeå universitet.
avhandlingen visar att snusare löpte 28 procent högre risk än icke-snusare att dö i förtid. Hjärt-kärlsjukdomar och övriga orsaker (andra än hjärt-kärlsjukdomar och cancer) stod för de flesta av dödsfallen. Även dödligheten i cancersjukdomar var något förhöjd. Före detta snusare hade också en förhöjd dödlighet, men den var lägre än bland aktiva snusare.
Exakt på vilket sätt snus orsakar högre dödlighet går inte att få svar på. I studierna gick det inte att se något tydligt samband mellan snusning och kända riskfaktorer för hjärt-kärlsjukdomar som övervikt, högt blodtryck, förhöjda blodfetter eller typ 2-diabetes.

nivån av en inflammatorisk markör i blodet var till och med något lägre än för icke-snusare. Däremot hade snusarna lägre nivå av D-vitamin i blodet, och i andra studier har låga D-vitaminnivåer visat sig vara kopplade till ökad förekomst av hjärt-kärlsjukdomar, depression och försämrad överlevnad.

källa : umeå universitet
Över 4 000 ettåringar i vissa Stockholmsområden erbjuds extra tidiga besök hos tandvården. Projektet pågår i områden där tandhälsan hos barn generellt är sämre än genomsnittet.
Syftet är att lära föräldrar att ta hand om barnens tänder och skapa en tidig relation till tandvården.
käl la : sveriges radio
Välkomna till Barntandvårdsdagar 2023:
Folktandvården inleder ett pilotprojekt i Sundsvall och Örnsköldsvik där intervallerna för kallelserna för barn och unga vuxna ökar med ett halvår. I stället satsas mer på tandvård för vuxna. Syftet är att behålla den egna tandvårdspersonalen. Pilotprojektet beräknas pågå i två år.
källa : sundsvalls tidning
nu har även Umeå en studerandepristagare! Då Tandhygienistprogrammet vid Umeå universitet har intag på våren examineras studenterna först vid årsskiftet, till skillnad från övriga utbildningar som är klara till sommaren.

sthf : s och tepe Munhygienprodukters studerandepris 2022 delades ut på avslutningsceremonin på Umeå universitet den 13 januari. Priset berättar att studenten gjort något extra eller har särskilda egenskaper som är särskilt värdefulla i tandhygienistyrket. Studerandepriset har delats ut en gång per år sedan 2013, till en student per lärosäte efter sex fullbordade terminer.

pristagare vid tandhygienistprogrammet vid umeå universitet 2022 : Johanna Bergström
motivering: Johanna visar förmåga och engagemang att hitta individuella lösningar och stötta patienter utifrån deras förutsättningar. Johanna är innovativ och genom sin förmåga till normkritiskt tänkande identifierar och strävar hon efter att överbrygga ojämlikhet till särskilt sårbara grupper. Johanna bidrar i sin roll som tandhygienist till en positiv utveckling av hållbarhet i tandvården.
Grattis Johanna!

Äntligen kan vi berätta att EKULF har blivit med en sprillans ny hemsida och webbshop!
Vi vill göra det ännu mer förmånligt för dig att handla munvårdsprodukter från oss. Därför har vi genomfört en helomvandling av vår webbshop, allt för att göra det så enkelt som möjligt för dig att ta del av EKULFs kompletta sortiment med prisvärda tand- och munvårdsprodukter.
Framöver kommer du dessutom kunna ta del av kanonerbjudanden varje månad på hemsidan.
BRETT SORTIMENT
Komplett sortiment med ca 500 olika artiklar i vår produktportfölj!
SNABB LEVERANS
Beställer du innan kl 11.00 skickar vi vanligtvis ordern samma dag.
SMIDIG BETALNING

Betala smidigt med Klarna som privatkund och faktura som företagskund!
Läs gärna mer om EKULF och om våra produkter på www.ekulf.com Önskar ni mer information mejla order@ekulf.se eller ring 011-14 40 30.
Forskare vid Karolinska institutet har tagit fram en lista på de vanligaste bakterierna vid svåra tandinfektioner. Studien kan bidra till ökad kunskap om sambandet mellan munbakterier och andra sjukdomar. Tidigare studier har visat tydliga kopplingar mellan munhälsa och flera folksjukdomar, bland annat cancer, hjärt-kärlsjukdom, diabetes och alzheimer, men det saknas longitudinella studier som visar vilka bakterier som finns i en tandeller käkbensinfektion.
– Här rapporterar vi för första gången den mikrobiella sammansättningen av bakterieinfektioner från prover som samlats in under en tioårsperiod i Stockholms län.
Resultaten visar att ett flertal munbakterieinfektioner med koppling till systemiska sjukdomar förekommer ständigt, och vissa har även ökat under det senaste decenniet i Stockholm, säger
Margaret Sällberg Chen, professor vid institutionen för odontologi vid Karolinska institutet.
De vanligaste grupperingarna av bakterier bland proverna var firmicutes, bacteroidetes, proteobacteria och actinobacteria.
Bland enskilda släkter av bakterier var de vanligaste streptococcus spp, prevotella spp och staphylococcus spp.
källa : karolinska institutet
Fredagen den 24 februari försvarar doktorand och leg. tandhygienist Elena Shmarina sin avhandling med titeln Salutogenic Factors for Oral Health among Older People vid Malmö universitet.
Opponent: Professor Kajsa Henning Abrahamsson, Göteborgs universitet.

Betygsnämnd: Professor Magnus Hakeberg, Göteborgs universitet. Docent Ulrika Lindmark, Karlstad universitet. Docent Katarina Sjögren Forss, Malmö universitet.
Ordförande vid disputa-
tionen: Professor Kristina Hellén-Halme, Malmö universitet.
tandvården behöver bli bättre på att informera om kostnader och behandlingsalternativ. Patienter har ofta dålig kännedom om tandvårdssystemet och de stöd som finns och färre än hälften av patienterna upplever att de får tillräcklig information om kostnader. Det visar rapporten »Tala om tänder« som Myndigheten för vård- och omsorgsanalys nyligen publicerat.
Närmare 5200 vuxna som besökt tandvården minst en gång de senaste tre åren har besvarat frågor via en enkät. Rapporten pekar på att många saknar information om behandlingsalternativ. Tandvården behöver bli bättre på att anpassa informationen till patienters olika behov och förmåga att ta till sig den.
malmö universitet hamnar på andra plats i världen i en studie av forskningsområdet temporomandibulär dysfunktion – TMD. Studien har analyserat forskning inom området, och rankningen visar bland annat produktivitet och citeringar per publikation.

I den bibliometriska studien hamnar Malmö universitet tvåa efter universitetet i Saõ Paulo. Lärosätet får speciellt bra resultat när det gäller antal citeringar per ensamförfattade artiklar. I samma rankning hamnar KI på femte plats och Århus universitet på sjätte plats.

Flera forskare vid Malmö universitet har ingått i ett internationellt konsortium där man tillsammans tagit fram en metod för att diagnosticera käkbesvär och orofacial smärta. Denna metod har senare vidareutvecklats av forskarna vid Malmö universitet i ett nationellt och internationellt samarbete. Metoden, som inkluderar både screening och diagnostik, lärs idag ut till såväl tandläkarstudenter som yrkesverksamma. Den är även implementerad i allmäntandvården i ett flertal svenska regioner.
källa : malmö universitet
den 1 januari höjdes taket i högkostnadsskyddet för läkemedel med 200 kronor, till 2 600 kronor. De apotekskunder som befinner sig på något av högkostnadstrappans steg vid årsskiftet och inte har uppnått frikort, får betala en engångssumma den första gången som de hämtar ut sina läkemedel på apotek under 2023.
källa : ehälsomyndigheten
»Har du blivit slagen, hotad eller utsatt för våld i nära relation?« Den frågan får alla patienter över 18 år när de besöker Folktandvården i Uppsala län.
Uppsala län är först i Sverige med att ställa den typen av frågor på rutin. Arbetssättet blev en del av den dagliga rutinen i maj förra året. Omkring 200 personer har vid sitt tandläkarbesök hos Region Uppsala uppgett att de är eller har varit drabbade av våld.
– Om man vet att det är en fråga som man ställer till alla patienter, likväl som med rökning, så blir det naturli-
gare, säger projektansvariga tandhygienistenen Kristin Markman.
Enligt Kristin Markman kan det finnas en fördel med att upprepa frågan vid varje besök, eftersom många våldsutsatta ofta svarar nej första gången.
– Våldsutsatta kan också ha en starkare tandvårdsrädsla, eftersom våldet kan göra sig påmint i till exempel käkskador.
Om en person uppger att hen är utsatt för våld kommer man tillsammans att hitta lämpligast hjälp.
–
blivit slagen,




EFFEKTIV RENGÖRING – SKONSAM MOT TANDKÖTTET!
KONISK FORM ger smidig åtkomst mellan tänderna
EXTRA MJUK SPETS


hjälper till att skydda tandköttet
HANDTAG MED
BÄTTRE GREPP och förlängningsbart skaft
STANDARDBORST för effektiv rengöring


NÅGRA AXPLOCK UR PROGRAMM ET
BRUSH UP: KLASSIFICERINGARNA FÖR PARODONTAL SJUKDOM.
Emelie Stenberg är doktorand vid Malmö universitet.
LET MY DATASET CHANGE YOUR MINDSET – SKAPA ÄR
VÄRLDENS STÖRSTA ODONTOLOGISKA KVALITETSREGISTER!. Lars Gahnberg, registerhållare Skapa, och Hans Östholm, biträdande registerhållare Skapa.
BRA ÄR DET NYA BÄST – VERKLIG MOTIVATION OCH ARBETSLUST. Olof Röhlander är författare och en inspiratör i världsklass och en av Sveriges mest hyllade talare genom tiderna.
VÄLKOMMEN!
Registreringen för deltagare och utställare är öppen på 2023.tandhygienistdagarna.se


I stora delar av USA skriker man efter tandhygienister. En utmaning är att regelverket ofta är olika i de femtio delstaterna. Vi besökte en tandhygienistskola i snabbt växande Las Vegas för att höra hur det fungerar där.
vi lämnar las vegas Boulevard, gatan där alla berömda hotell och casinon ligger, och kör förbi en massa bröllopskapell som erbjuder en Elvis Presley-kopia som vittne. Eller Marilyn Monroe. Neonljusen blir färre och plötsligt är vi framme vid College of Southern Nevada.
Missy Abel, som med titeln Dental Hygiene Programs Director sedan många år är ansvarig för tandhygienistutbildningen, tar emot oss.
Hon skrattar när vi säger att det är förvirrande för oss att det finns så olika regler i samma land.
– Tro mig, det är inte enkelt för oss heller. Ta bara det här med anestesi. Jag utbildade mig i delstaten Idaho där anestesi ingick i utbildningen. När jag sedan började arbeta här i delstaten Nevada var det inte tillåtet för tandhygienister att ge smärtlindring. Hon funderar en stund.

– Man kan förenklat säga att de västra delstaterna alltid har varit mer progressiva än de östra. Just anestesi är ett bra exempel. Där var delstaten Washington, längst uppe i nordvästra hörnet av USA, först att låta det ingå i tandhygienisters arbetsuppgifter. Därifrån spreds det. Hon ser frågan »varför?« i våra ögon och svarar innan den ens ställts:
– Egentligen var den utvecklingen ganska logisk. Det fanns helt enkelt färre tandläkare och tandhygienister i flera västra delstater, så det öppnade för att tandhygienister där fick mer och mer förtroende. Idag är förtroendet mer lika i landet, men fortfarande finns skillnader i arbetsuppgifter.
eftersom college of southern nevada är ett så kallat Community college, som är offentligt drivna och påminner lite om svenska folkhögskolor, är skolavgifterna betydligt lägre än på privata college och universitet. Men ändå är ekonomi en faktor. Eleverna måste köpa utrustning och kläder. Det kan kosta 10 000 dollar (cirka 100 000 kronor), men går ofta att sälja efter examen till kliniken där hygienisten anställs om eleven får jobb. Som det är nu, med brist på tandhygienister, får de flesta jobb. De tjänar bra, 75 000–80 000 dollar per år (cirka 750 000–800 000 kronor), så många tycker att det är värt investeringen.
– Eleverna är i olika åldrar och har olika etniska bakgrunder. Den äldsta är 54 år och en hel del är förstås riktigt unga. Många är runt 40 år efter att ha varit hemma med barn. Kvinnor dominerar, men just nu är tre av eleverna män, berättar Missy Abel och presenterar oss för en av dem, Steven Glad.
Han var hemma med barnen så att frun kunde arbeta, vilket inte är helt vanligt i USA, men har nu tagit tag i en egen karriär.
– Jag tror tandhygienist blir väldigt bra. Jag gillar skolan och känner att jag lär mig mycket, säger han.
Utbildningen är tvåårig med väldigt mycket praktiskt i arbete i skolans egen klinik. Vi träffar några av lärarna – Cara Kirby, Dorianne Bautista, Liz Diaz – som alla är engagerade i yrket, vilket inte minst märks på nyfikna
Efter de två åren går det att gå vidare och läsa två år till för att ta en kandidatexamen inom oral hälsa vilket öppnar för fler arbetsmöjligheter, bland annat som lärare.

las vegas ser på håll inte särskilt stort ut där den ligger i en dal i Mojaveöknen, men bergen eller vidderna lurar ögat. Spelstaden som byggdes av maffian hade 1950 fått svindlande 35 000 invånare, men har nu nått 2,7 miljoner och fortsätter växa.


frågor om hur det fungerar i Sverige. Va? Gratis utbildning? Va? Gratis barntandvård?
De berättar att första terminen mest är grundläggande kunskap. Ändå kommer elevernas första patienter in tidigt i undervisningen och är ofta syskon eller föräldrar – och redan andra terminen har de »riktiga« patienter.
– Det är billigare för patienter att gå till oss på skolan men tar förstås längre tid. Många av våra patienter har dålig ekonomi, men mycket tid. Här kan de betala 20 dollar, men kanske behöver komma hit fyra gånger, för något som går på ett besök men kostar 1 200 dollar privat. Det vinner båda parter på, säger Missy Abel.
Det innebär att klyftorna är stora. Det ser man även på tandstatusen. Kring alla lyxiga hotell och casinon är det mycket blekta tänder och raka tandrader, om man säger så. Ju längre bort man kommer från glamouren, desto gulare blir tänderna och porslinsfasaderna allt färre.
Missy Abel själv valde för övrigt yrket för att hon själv hade så många problem med tänderna.
– Våra elever är engagerade i samhället. Tandvård får man i USA genom sina försäkringar, men det innebär att många oförsäkrade, även barn, inte får någon tandvård alls. Där kan vi göra en insats. Företagen Colgate och Oral-B hjälper till mycket. Eleverna gör frivilligt arbete på bland annat ett kvinnofängelse och genom Future Smiles, en ideell organisation som hjälper barn från fattigare familjer med tandvård. Den startades faktiskt av en tidigare elev här.






Missy Abel om…
… distansundervisning:
»Vi har ingen sådan nu. Under pandemin hade vi en del, men vi såg att det var svårt att få det att fungera. Vi gjorde vad vi kunde, men många elever hoppade av. Det fuskades dessutom mycket. Jag lider verkligen med de årskullarna.«
… adha (american dental hygienists association): »Det är det närmaste en fackförening vi kan komma. De erbjuder utbildning och stöd till medlemmar som vill gå vidare. Jag önskar att alla löste medlemskap, men tyvärr är det många som arbetar deltid som struntar i det. Jag betonar för mina elever att det är deras kamp att utveckla yrket, att de måste vara aktiva själva.«



… blodtryck :
»Utvecklingen för tandhygienister är stor. Relativt nytt är att vi alltid tar blodtrycket på patienter, eftersom vi numera vet att munhälsa hänger ihop med övrig hälsa.«
… egen praktik :
»De flesta tandhygienister arbetar hos en tandläkare. Det finns ett par egna praktiker, men de måste ändå vara knutna till en tandläkare. I delstaterna Colorado och Kalifornien kan tandhygienister driva oberoende kliniker. Det kanske kommer hit också, men tandläkarförbundet som står emot är stort och starkt...«
… sitt yrkesval :
»Jag hade problem med tänderna som barn. Min mamma skojade att jag måste jobba med tandvård för vi hade inte råd annars och, well, here I am…«
… sitt mest intressanta jobb :
»Jag arbetade på Marshallöarna (ögrupp i Stilla havet) med att sköta amerikanska stridspiloters tänder. De får inte flyga om de har tandproblem så de måste ständigt undersökas. När jag hade tid över hjälpte jag även lokalbefolkningen med förebyggande tandvård. Det var omvälvande och något jag aldrig glömmer.«
i våra löneavtal , oavsett om det är inom folktandvård eller den privata sektorn, är dialogen mellan arbetsgivare och medarbetare central. Utgångspunkten är att det är ni lokalt som känner till förutsättningarna – utmaningarna och möjligheterna – bäst. Lönesamtal är till sin natur tillbakablickande, att man ser bakåt på uppnådda prestationer.
vid ett lönesamtal ska diskussionen utgå från lönekriterierna på arbetsplatsen då detta utgör måttstocken för lönen. Lönekriterierna är ett sätt att bryta ned verksamhetens mål i olika – i bästa fall – mätbara variabler. I samtalet är det din uppgift att förklara för din chef vad du har uppnått i förhållande till lönekriterierna och hur mycket du tycker att det här är värt.
inför lönesamtalet kan du förbereda dig genom att tänka tillbaka på året som har gått och vad du har uppnått i förhållande till lönekriterierna. Ta hjälpa av lönekriterierna och skriv ned dina prestationer i samma språk som kriterierna är formulerade. Förhoppningsvis har du anteckningar från ditt senaste medarbetarsamtal som du kan återkoppla

till. Lönen har flera beståndsdelar där din prestation är en av dessa, men du befinner dig också på en arbetsmarknad där du påverkas av marknadskrafter. För att få en förståelse av hur just din arbetsmarknad ser ut kan du logga in på SRAT:s hemsida och titta i Saco Lönesök. Där samlas informationen från löneenkäten som är synnerligen viktig att så många som möjligt svarar på –bland annat för att hjälpa andra tandhygienister.
lönesamtalet ska föras med din lönesättande chef, det vill säga den chef med mandat såväl som befogenhet att sätta din lön. Om den på andra sidan bordet saknar befogenheten bör du vända dig till fackligt förtroendevald för råd.
det är viktigt att komma ihåg att samtalet handlar om dig – ditt uppdrag, din kompetens och ditt resultat. Du kan då argumentera för din sak utifrån verksamheten med dess utmaningar och möjligheter. Kom ihåg att du ska förstå fullt ut vad chefen anser om din prestation och hur hen ser på din framtida löneutveckling.
ibland kan det vara så att du inte är helt nöjd med lönesamtalet. Dels kan det bero på samtalets innehåll, dels på att du får ett lönebesked du inte är nöjd med. Det är då viktigt att du förmedlar till din chef att du tycker att lönen inte motsvarar det du har presterat eller att du inte anser att din lön är marknadsmässig. Du kan också be att få en åtgärdsplan. Vad anser chefen att du utifrån lönekriterierna behöver förbättra för att kunna höja din lön till en viss nivå?
kom ihåg – förbered dig, var konstruktiv, rak och tydlig. Lycka till!
TEXT: SVERKER JUTVIK sverker.jutvik@srat.se






Högre nikotinhalt
Vitt snus har funnits till försäljning i Sverige sedan 2016. Det liknar portionspåsar med brunt snus och kallas ibland för nikotinpåsar eller nikotinportioner.

Snusandet fortsätter att öka bland Sveriges unga. Inte minst det vita snuset. Enligt en stor nationell skolundersökning har 22 procent av eleverna i nian och 40 procent på gymnasiet någon gång testat vitt snus. Samtidigt höjs allt fler röster om nikotinets hälsorisker.
de senaste rapporterna om svenskarnas tobaks- och nikotinbruk talar sitt tydliga språk. Rökningen går ner. Snusandet upp. Särskilt ökar det bland ungdomar, i huvudsak bland tjejer, vilket brukar kopplas ihop med det vita, så kallade tobaksfria snuset. Det har, sedan det lanserades 2016, marknadsförts genom influencers och andra kända personer på ett sätt som uppenbart riktar sig till en kvinnlig målgrupp. Snusdosan framställs som en snygg accessoar som kan matcha både outfit och make-up. Själva snuset beskrivs som fräscht och gott. Inte alls som det brunrinniga snus som under årens lopp främst brukats av män.
CAN, Centralförbundet för alkohol- och narkotikaupplysning, har i sina skolundersökningar de senaste fem åren sett en kraftig ökning av snusandet bland både niondeklassare och gymnasietvåor. När de släppte 2022 års resultat stod det klart att uppgången håller i sig. Av niorna uppgav 11 procent att de snusar, vilket kan jämföras med 5 procent 2017.
Statistik för det nya vita nikotinsnuset har bara funnits i några år. Första gången CAN inkluderade frågor om vitt snus var 2021.Då uppgav 18 procent av niorna att de hade testat och 2022 var det 22 procent. Bland gymnasieeleverna har det gått från 34 till 40 procent.
Trenden bekräftas av Folkhälsomyndigheten, som förra året började med frågor om det vita snuset i sin nationella folkhälsoenkät Hälsa på lika villkor. Resultatet visar att det vita snuset används av nästan var femte kvinna och var tionde man i åldersgruppen 16–29 år. Medan vanligt tobakssnus brukas av ungefär var femte man och var tjugonde kvinna.
Fyra gånger högre nikotinhalt
Louise Adermark är docent i neurobiologi vid Göteborgs universitet. Hon och hennes forskarteam undersöker framför allt hur nikotinet påverkar hjärnan – och hon ser med oro på det vita snusets framfart. Många av de unga som nu börjar snusa lockas in i ett livslångt beroende och vilka långtidseffekter det kommer få kan ingen svara på idag.

– Nikotinhalterna i det vita snuset kan vara väldigt höga, ibland upp mot fyra gånger så höga som i vanligt snus. Det leder snabbt till ett nikotinberoende, säger Louise Adermark.
Vad gör då nikotinet med kroppen? Louise Adermark säger att många tror att det enbart är tobaken som är skadlig och att produkter som klassas som tobaksfria är säkra ur hälsosynpunkt. Men nikotin påverkar flera av kroppens system. Inte minst hjärta och kärl. Det frisätter adrenalin, ökar blodtryck och
hjärtfrekvens och på sikt kan nikotinberoendet leda till stelare blodkärl. Nikotin under graviditet gör att blodet flödar sämre i livmodern och moderkakan, vilket kan leda till missfall eller att barnet inte får den näring det behöver och föds med låg vikt. Även sårläkningen försämras och det finns kopplingar till diabetes typ 2.
Dessutom tycks nikotin öka risken för andra typer av beroenden och för psykisk ohälsa.
– Det är vanligt med nikotinanvändning bland individer som missbrukar alkohol. Råttor som exponeras för nikotin ökar sitt alkoholintag och det ökade suget kvarstår även när vi tar bort nikotinet, säger Louise Adermark.
Det verkar som att nikotinet »bygger om« våra hjärnor, och den forskning som Louise Adermark kommer att ägna sig åt framöver är att försöka förstå nikotinets koppling till psykisk ohälsa, som ångest, och neuropsykiatriska funktionsnedsättningar som ADHD.
– Vi vill veta om snusare kan få beteendeförändringar och bli mer risktagande, men det är svårt att veta vad som är hönan och vad som är ägget, säger hon.
Något som ofta framhålls i debatten är att det vita snuset skulle ha stora hälsofördelar jämfört med de gamla tobaksprodukterna. Särskilt i rökavvänjningssyfte. Men i CAN:s undersökning hade en betydande andel av de skolungdomar som dagligen använde de nya nikotinprodukterna varken rökt eller snusat något annat innan de började. Så för många handlar det inte alls om att sluta röka. Istället blir snuset en inkörsport till andra nikotinprodukter.
– Många lyfter att »det är i alla fall bättre än att röka«. Men vi måste ju faktiskt inte använda nikotin alls. Har du börjat med en nikotinprodukt ökar dessutom risken att du testar andra, som e-cigaretter eller vanliga cigaretter. Där finns en korrelation, säger Louise Adermark.
Men visst försvinner några av tobakens hälsofarliga ämnen när nikotinet, som trots att snuset kallas tobaksfritt ändå utvinns från tobaksplantan, renas från de bruna tobaksbladen.
– Vi blir av med vissa cancerogena ämnen, en del tungmetaller och bekämpningsmedel som finns i tobaken. Det är det positi-
va, säger Louise Adermark och fortsätter:
– Men det svårt att veta hur mycket nikotin ett snus innehåller och vilket ph-värde det har, vilket också påverkar hur munslemhinnan tar upp nikotinet. Nikotin i stora mängder är ett dödligt gift. Så om du absolut måste snusa – välj ett snus med så låg nikotinhalt som möjligt.
Stora kunskapsluckor vad gäller vitt snus När det kommer till det vita snusets effekter specifikt på munhälsan är kunskapsluckorna ganska stora. Känt för de flesta är att det irriterar slemhinnan och det kan bli ilsket rött där prillan brukar läggas. För tandvårdspersonal är det ofta lätt att se vem som snusar och inte.
Jan Hirsch är professor emeritus, tandläkare och specialist inom käkkirurgi. Han har ägnat en stor del av sitt yrkesliv åt cancer i munhålan och sambandet med tobaksbruk.

Han är kritisk till att allt fler ungdomar använder vitt snus, och berättar att hans egen forskargrupp tidigt visade att nikotin påverkar munnens slemhinna. De kunde se att nikotintabletter framkallade synliga slemhinneförändringar som också sågs i vävnadsprover flera månader efter avslut.
– Snuset är svensk tradition och en helig ko som man inte avlivar så lätt. Det har skrivits mycket om hälsoriskerna med snus, nu senast i en avhandling från Umeå universitet om att snusare har ökad risk att dö i förtid. Men
tobaksindustrin kör sitt race och även tandvårdspersonal snusar, vilket inte borde vara tillåtet på jobbet, säger han.
För den som önskar ändring finns numer ett visst hopp. Jan Hirsch är en av flera som återkommande höjt rösten och efterfrågat ny lagstiftning på området. Främst för att skydda barn och unga från nikotinets skadliga verkningar.
Sedan i augusti 2022 finns en ny lagstiftning på plats. Den innebär både en 18-årsgräns för att köpa vitt snus och ett förbud att marknadsföra produkten till personer under 25 år.

martina zetterqvist är utredare på CAN och redaktör för den senaste rapporten. Hon påpekar att CAN:s skolundersökning gjordes innan lagändringen trädde i kraft, något som även gäller Folkhälsomyndighetens senaste siffror och statistik.
Andelen elever som använt vitt snus någon gång respektive senaste 30 dagarna, efter kön och årskurs. 2022
– Det blir intressant att fortsätta följa utvecklingen för att se om och hur lagändringen påverkar, säger Martina Zetterqvist i ett pressmeddelande från CAN.
TEXT: CAMILLA ADOLFSSON
– Snuset är svensk tradition och en helig ko som man inte avlivar så lätt.Jan Hirsch foto : micke hirsch
1 SymGurad CD (phenylpropanol, o-cymen-5-ol & decylene glycol) och Aloe Vera.

2 Tetrasodium pyrophosphate, panthenol och cetylpyridiniumchloride.
Vår vision med Flux är att munhälsa ska vara kul! Med en hög fluorhalt ger Flux starka tänder och hjälper till att förebygga karies. Produktserien har vuxit under åren och omfattar idag bland annat både fluorskölj, tandkräm och tuggummin för både vuxna och barn. Vi vill rikta ett tack till dig som jobbar inom tandvården för att du tillsammans med oss jobbar för att förbättra munhälsan i Sverige, tack!
Nyheter från Flux!
Nu finns serien Flux+. Dessa produkter ger en extra fördel, förutom att den verkar mot karies med innehållet om 0,2% NaF.




Den extra fördelen på respektive produkt är:
• Flux+ Gum Care: Lugnar och skyddar känsligt tandkött1
• Flux+ Prevent Plaque: Förebygger och motverkar plack2





































Ytterligare en nyhet från Flux är att de populära Flux Drops nu även finns med smaken Citron/Lime.



Flux finns på apotek, i matbutiker och hos många tandvårdskliniker. Produkterna är fria från alkohol och andra onödiga tillsatser.
Som ett komplement till daglig tandborstning, minst två gånger per dag. Stöder Sveriges Tandläkarförbund användningen av munskölj som innehåller fluor.
Parodontitens utbredning och svårighetsgrad har ökat bland yngre. Andelen patienter med avancerad parodontit som inte behandlats har ökat. Nära hälften av patienter med djupa tandköttsfickor får ingen sjukdomsbehandling.
grund för dessa påståenden står att finna i SKaPa-registret (Svenskt kvalitetsregister för karies och parodontit) dit alla folktandvårdskliniker, kliniker inom Praktikertjänst och vissa fristående privata tandvårdsmottagningar rapporterar. Björn Klinge, välkänd professor i parodontologi, var moderator för seminariet där den svenska parodontalvården diskuterades.
kristina edman, medicine doktor, tandhygienist och forskningsstrateg i Folktandvården Dalarna visade data från de tvärsnittsstudier som gjorts i regionen vart femte år sedan 1983. I studierna redovisas bland annat tandsten synlig på röntgenbilder och alveolar benförlust mätt på röntgenbilder. Mellan åren 1993 och 2003 minskade tandstensförekomsten från 44 procent till 13 procent. Därefter har den ökat igen till 38 procent vid den senaste mätningen 2018. Andelen individer utan någon alveolär benförlust ökade från 48 procent 1983 till 75 procent 2008. År 2018 hade siffran sjunkit till 58 procent. Andelen med moderat benförlust minskade från 45 procent 2018 till 17 procent 2008. Tio år senare var andelen 37 procent. Hos 35-åringarna skedde en fördubbling av moderat alveolär
benförlust mellan 2013 och 2018, från 3 procent till 6 procent och det skedde en kraftig ökning av tandstensförekomst, vilket kan indikera att denna grupp bör ses som en riskgrupp i tandvården.
Hur har det blivit så här? – Vi kan ju detta, egentligen. Edman menade att en orsak kan vara tandhygienisters förändrade arbetsuppgifter, bland annat till följd av bristen på tandläkare. Tidigare ägnade tandhygienister en stor del av sin kliniska tid till behandling av parodontit, idag har andra typer av behandlingar tagit över för många.
anna liss , disputerad tandhygienist vid specialistkliniken för parodontologi, visade i sin avhandling att 70 procent av fördjupade tandköttsfickor förslöts av icke-kirurgisk behandling hos tandhygienist. I sitt projekt undersökte hon även faktorer av betydelse för kvaliteten på tandhygienisters behandling av patienter med parodontit. Studien bestod av en enkätstudie, en klinisk fältstudie och en intervjustudie. Tandhygienisterna ansåg att evidensbaserad kunskap och riktlinjer är viktiga men inte närvarande i det dagliga arbetet. De saknade forum för diskussioner kring ny kunskap. Tandhygienis -
terna upplevde sin professions autonomi som villkorad av ekonomiska och organisatoriska resurser. De upplevde att fokus i organisationen är ekonomi snarare än odontologi. De upplevde tidspress i arbetet, att behandlingen inte alltid kunde utföras som de skulle ha önskat. Tandhygienisterna efterlyste även stöd och samverkan med andra tandvårdsprofessioner. Ansvaret för patienter med parodontit lämpades ofta över på tandhygienisterna.
ann - marie roos jansåker , docent och specialist i parodontologi, kunde bekräfta delar av resultaten i Anna Liss forskning genom ett projekt riktat till tandhygienister som genomförts i Skåne, där Roos Jansåker är verksam. Tandhygienisterna uppgav tidsbrist, att längden på bokade tider kortades av i receptionen, de saknade tid för reflektion och de uppgav en bristande samverkan med tandläkare vid parodontal behandling.
björn klinge ställde sig frågan om tandvården övergivit sjukdomsbehandling till förmån för mer lönsamma åtgärder. En situation som även diskuterats i The Lancet (Oral diseases: a global public health challenge).
Roos Jansåker föreslår att tandvården behöver ägna ett större intresse åt riskbedömning och patientutbildning. Hon föreslår även att korta konsultmöten, såsom inom ortodontin, med parodontolog, patient, tandläkare och tandhygienist skulle kunna vara ett stöd för behandlare på klinikerna.


anna bogren, specialist i parodontologi, universitetslektor vid Umeå universitet och ordförande i Svensk förening för parodontologi och implantologi menar att parodontologin måste återta sin plats i svensk tandvård. Tandvårdsorganisationer behöver jobba tillsammans med vårdkvalitetsutveckling. Svensk förening för parodontologi och implantologi har tagit ett första
steg för samverkan med Sveriges Tandhygienister gällande ett utbildningsprojekt. Vi väntar med spänning.
TEXT: MARIE SAND
Är strukturerad klassificering av kariessjukdom en naturlig del av ett personcentrerat och sammanhållet vårdförlopp? Nu vill man med ett nytt arbetssätt över hela landet få fokus på individens kariessjukdom, inte på den kariesskadade tanden.
tre orala tillstånd finns med i World Health Organization’s (WHO) lista över världens tio vanligaste icke smittsamma sjukdomar (NCDs, Non Communicable Diseases) – obehandlad karies, allvarlig parodontit och omfattande tandförlust. Nästan halva jordens befolkning, 3,9 miljarder, är påverkad av dessa tillstånd och kostnaderna för individer och samhälle är enorma. Karies är en ojämlik sjukdom. Socioekonomiskt svaga grupper är överrepresenterade bland individer med karies. Karies –en klassfråga skulle följaktligen också ha kunnat vara rubrik för seminariet. Moderator var Ulf Söderström, bland annat senior strateg i Region Västerbotten, medlem i Svensk samhällsodontologisk förening (SSOF) och Norra sjukvårdsregionens representant i Nationellt programområde (NPO) Tandvård.
Dagens riskvärderingssystem är inte optimala. För stor vikt läggs vid tandens sjukdomsutveckling i stället för individens och preventiva behandlingsinsatser upplevs som för ospecifika.
NPO tandvård tillsatte 2019 en nationell arbetsgrupp (NAG) med uppdrag att ta fram:

• en modell för strukturerat omhändertagande av patienter med återkommande karies
• barriärer som finns
• en modell för framgångsrik implementering samt
• mätbara indikatorer.
NAG har nu rapporterat följande till NPO tandvård:
• en strukturerad modell för omhändertagande av patienter med okontrollerad karies har tagits fram
• förslag att SKaPa-registret (Svenskt kvalitetsregister för karies och parodontit) används för utforskning av förekomst av okontrollerad kariessjukdom
• förslag att nya tillstånd och åtgärder samt en uppföljningskod införs för uppföljning av kariessjukdom
• förslag att bilda ett finansierat, samordnat nätverk med expertstöd i syfte att utveckla kariesbehandling.


staten och sveriges kommuner och Regioner (SKR) har tecknat en överenskommelse om att ta fram personcentrerade och sammanhållna vårdförlopp inom olika sjukdomsområden i syfte att skapa en jämlik och effektiv vård baserad på bästa tillgängliga kunskap. I oktober 2022 godkände SKR NPO tandvårds ansökan om ett personcentrerat och sammanhållet vårdförlopp för sjukdomen karies, det första godkända inom tandvård. Är strukturerad klassificering av kariessjukdom en naturlig del av ett personcentrerat och sammanhållet vårdförlopp?
Svensk Förening för Cariologi har arbetat med frågan om varför tandvården inte lyckas behandla kariessjukdom bättre. Dan Ericson, seniorprofessor i kariologi vid odontologiska fakulteten vid Malmö universitet, presenterade föreningens system för klassificering och prognosbedömning av kariessjukdom hos den enskilda individen. Systemet bygger på samma princip som den nya klassificeringen av parodontal sjukdom och kan vara en startpunkt i ett personcentrerat och sammanhållet vårdförlopp för sjukdomen karies.
allvarlighetsgraden klassificeras i låg / måttlig / hög / extrem med hjälp av att:
• den kumulativa skadeprofilen identifieras genom att patientens DMF-T (Decayed Missing Filled Teeth) i förhållande till ålder placeras i SKaPa-registrets graf, där patienten hamnar i grön, gul eller röd zon
• komplexiteten bedöms efter vilka tandytor som involveras
• utbredningen bedöms efter vilka tandgrupper som är drabbade.
prognosen bedöms som god / tveksam / dålig utifrån:
• de kliniska kriterierna progression och aktivitet i initiala eller manifesta kariesangrepp
• kost (intagsfrekvens och sockerinnehåll)
• salivsekretion
• kariesrelaterade bakterier
• fluorider
• plack
• medicinska / psykosociala / ekonomiska / sociala faktorer, tandvårdsvanor med mera som kan påverka sjukdomen och dess förlopp.
maria holmgren, tandläkare och Karin Green, tandhygienist, båda kliniskt verksamma vid Folktandvården Eyra och Kariologimottagningen i Region Örebro län tog vid efter Dan Ericson. Båda har även centrala uppdrag som handledare för allmäntandläkare respektive tandhygieniststudenter. De berättade om hur klassificeringssystemet för karies har testats vid kariologimottagningen.
SKaPa-registrets graf över DMF-T används bland annat som ett kommunikationsverktyg vid basundersökningen, där patienten kan få en uppfattning om hur den eg na situationen är i förhållande till »genomsnittet« för sin ålder. Vid en kompletterande undersökning erbjuds utförlig information och utredning av orsaker till kariessjukdomen.
Vid seminariet presenterades en orsaksutredning »by the book« med kostdagbok, salivprov och fördjupad anamnes. Med hjälp av de data som kommer fram vid orsaksutredningen kan patienten ringas in i diagrammen för allvarlighetsgrad och prognos. Om allvarlighetsgraden är extrem och prognosen dålig erbjuds patienten kvalificerat rådgivande samtal där patientens kunskap, förväntningar, resurser och begränsningar utforskas.
I ett patientexempel beskrevs en individuell behandlings plan som innefattade hög dos fluoridtandkräm om 5000 ppm två gånger per dag, natriumfluo ridsköljning 0,2 % mitt på dagen, kostförändringar och uppföljning upprättas. Målet för behandling är att stoppa kariesprogression.
seminariet avslutades med en stund för reflektioner och frågor. Som kliniskt verksam tandhygienist i över 30 år ser jag många fördelar med ett strukturerat klassificeringssystem även för karies och jag stimuleras av tanken på en ny väg för kommunikation med patienten genom att använda SKaPa-registrets graf över DMF-T.
Däremot erbjöds inget nytt under solen avseende omhändertagande av patienter med karies. Tyvärr finns inte längre enkla och prisvärda metoder för bakteriologisk analys eller paraffinbitar för stimulerad sekretionsmätning tillgängliga på den svenska dentalmarknaden, något som inte belystes under seminariet. (Däremot finns det i Tyskland, läs mer på www.kariesscreentest.de/en/home)
I decennier har tandhygienister utbildats i behandling av patienter med karies. Om orsaksinriktad behandling av karies inte sker kanske svaret kan sökas i vårdgivarnas organisation? Dessutom behöver vi förflytta oss ut från klinikerna till det omgivande samhället om vi ska lyckas bemästra karies i befolkningen (se referat Samverkan – är det ett sätt att tillsammans överbrygga gapen?).
ÅLDER
Medeltal med +/-1 och +/-2 standarddeviationer för DMFT, karierade, fyllda eller saknade tänder, för åldrarna 10–95 år (2021). Om man placerar in patientens DMF i diagrammet kan det användas vid parientkontakt för att skapa ett samtal om den aktuella tandskadesituationen.

Kumulativ skadeprofil – patientens ålder respektive summan av antal karierade / förlorade tänder till följd av karies eller endodonti / fyllda tänder prickas i diagrammet där man kan se patientens status i förhållande till sina jämnåriga. Resultatet används vid klassificering av karies. Data i diagrammet kommer från SKaPa Årsrapport 2021 (www. skapareg.se).

Klassificering av kariesskador: Patientens status prickas i kolumnerna för bedömning av kariessjukdomens allvarlighetsgrad. Den allvarligaste kolumnen bestämmer oftast vilket stadium patienten kategoriseras i.
Prognosgradering av kariessjukdom: Patientens status prickas i kolumnerna för prognosbedömning. Den sämsta kolumnen bestämmer oftast prognosen.

WHO rekommenderar att tandvården skiftar fokus från reparation till prevention. Ju tidigare sjukdom kan hindras, desto bättre effekt på folkhälsan. Två preventionsprojekt presenterades under seminariet.
obehandlade kaviteter till följd av karies i permanenta tänder är världens vanligaste hälsoproblem. En halv miljard av världens barn har karies i sina mjölktänder. Grav parodontit drabbar nästan var femte vuxen person globalt. Ända från tidig barndom råder ett starkt samband mellan låg socioekonomisk status och oral ohälsa. Högt sockerintag, tobaksbruk och alkohol är gemensamma riskfaktorer för munnens sjukdomar och övriga dominerande icke smittsamma sjukdomar (NCDs, Non Communicable Diseases) det vill säga hjärt- och kärlsjukdomar, cancersjukdomar, kroniska luftvägssjukdomar och diabetes.
Folkhälsointerventioner inriktade på dessa riskfaktorer kan minska sjukdomsbördan. WHO (World Health Organization) uppmanar därför medlemsländerna att oral hälsa inkluderas i NCD-strategier och att interventioner riktade mot oral hälsa ska ingå i ländernas allmänna hälsoprogram (Seventy-fourth World Health Assembly, 2021).
folkhälsans bestämningsfaktorer och interventioner illustreras ofta av en flod. Vid källan, upstreams, finns beslut på övergripande nivå såsom policies, lagar och förordningar. Midstreams sker prevention med insatser i boenden, familjer, skolor och så vidare. Downstreams repareras uppkomna skador på individnivå och insatser som enbart sker där tenderar att öka hälsoklyftorna snarare än att minska dem. WHO:s rekommendation är att tandvården skiftar fokus från det traditionellt reparativa till ett mer preventivt. Ju högre upp i floden, desto bättre effekt på folkhälsan. Det svenska folkhälsomålet att påverkbara hälsoklyftor ska vara slutna inom en generation röstades igenom i riksdagen 2018.
vid seminariet, som arrangerades av Socialstyrelsen i samverkan med Svensk samhällsodontologisk förening (SSOF) och Hälsodontologiska enheten vid Folktandvården i Västra Götalandsregionen (VGR), fick åhörarna ta del av två projekt midstreams, det ena inriktat på äldre (TAIK) och det andra på små barn (Hälsopromotörer i tandvården). Moderatorer var Sara Olsson, tandhygienist och verksamhetsutvecklare vid Hälsoodontologiska enheten i VGR samt Katharina Wretlind, docent i kariologi, folkhälsostrateg i VGR samt vice ordförande i SSOF.
jessica persson, tandhygienist vid Hälsoodontologiska enheten och projektledare för TAIK (tandhygienist i kommunal verksamhet) samt tandhygienist Veronica Öst, TAIK i Kungälv, berättade om projektet, som startade med ett pilotprojekt i Mariestad för nästan tio år sedan. Projektet skalades upp 2018 och omfattar nu fem tandhygienister som vardera arbetar halvtid icke kliniskt i fyra kommuner i Västra Götaland. Inriktningen är invånare som är äldre än 65 år, oberoende såväl som sköra eller beroende. Syftet är att tandhygienisterna ska vara en integrerad del i den kommunala verksamheten och säkra kompetens och kvalitet vad gäller munvård i vård och omsorg, samt vara sakkunniga i tandvårdsfrågor. Målet med projektet är att främja en god munhälsa för regionens årsrika befolkning. Du kan läsa mer om TAIK-projektet i TandhygienistTidningen nr 6/2022.

stina bertling, folkhälsovetare och projektledare för »Hälsopromotörer i folktandvården« berättade om projektet som riktar sig till barn upp till sex års ålder. Bakgrunden till projektet var att trots tandvårdens alla insatser sågs under flera år en ökad kariesfrekvens hos sexåringar. År 2019 startade ett 18 månader långt pilotprojekt med en hälsopromotör för att 2021 utökas till ett treårigt projekt med sex hälsopromotörer på elva kliniker. Målgruppen är barn som har karies eller har en ökad risk för karies. Hälsopromotörerna håller hälsosamtal med familjer i målgruppen, perspektivet är salutogent vilket innebär att fokusera på det friska. Dessutom ska hälsopromotörerna samverka med andra i kommunen, som möter samma målgrupp, såsom familjecentraler eller förskolor samt fungera som kompetensresurs för tandvården vad gäller beteendeförändring. Mötena med föräldrar har varit uppskattade med önskemål om fler träffar och diskussioner som inte enbart rör munhälsan, såsom att sätta gränser för sitt barn.
peter lundholm , tandläkare och sakkunnig hos Socialstyrelsen, lyfte att de Nationella riktlinjerna med rekommendationer, indikatorer, målnivåer och utvärdering är exempel på policies upstreams. Han visade även några filmklipp från en intervju med Richard G Watt, professor i Dental Public Health och Director för WHO Collaborating Centre in Oral Health Inequalities and Public Health vid University college i London, där bland annat projekten i VGR diskuterades. Watts såg en stor potential i att tandvården har flyttat ut från klinikerna midstreams till familjers och äldres hemmiljö. Peter Lundholm beklagade att systemen idag inte riktigt stödjer samverkan runt äldre. TAIK-projektet visar glädjande nog att de organisatoriska mellanrummen trots allt går att överbrygga, om viljan finns.
TEXT: MARIE SAND
Zendium Professional Pro Gums + Sensitivity
• Lindrar och förebygger känsliga tänder
• Förebygger tandköttsproblem
Zendium Professional Pro Gums + Clinical Fresh


• Förebygger tandköttsproblem
• Förebygger halitos i upp till 12 timmar
De två nya Zendium tandkrämerna är:
• Effektiva mot anaeroba bakterier
• Minskar tillväxten av patogena bakterier
i den mogna biofilmen
• Främjar gingival hälsa och en balanserad oral mikrobiom* • Har en optimerad formulering med en högre koncentration av glukos oxidas

Innehåller 1450 ppm NaF
Med Zendium Professional kan du ta hand om planeten samtidigt som du tar hand om ditt tandkött. Se här hur:
90% återvunnen
kartong för förpackning
99,9% av tandkrämen
är biologiskt nedbrytbar Minst 60% bioplast i tandkrämstuberna

Var jobbar du och vilken roll har du där?
Jag är verksamhetsutvecklare inom Folktandvården Västra Gö taland på Hälsoodontologiska enheten. Där arbetar jag mest med frågor som rör barn och ungdomstandvård med syfte att förbättra munhälsa.
Vi arbetar mycket med samverkan med övriga professioner kring barnen till exempel barnhälsovård, familjecentraler och skolan för att utveckla folktandvårdens preventiva arbete. Vi tar även fram riktlinjer och behandlingsstrategier samt följer upp det arbete som görs i regionen. Nätverksträffar för vår personal med olika arbetsuppgifter på sina kliniker samt utbildningar och föreläsningar fyller också dagarna. Tillsammans med mina kollegor, som till professionen är tandhygienister, tandläkare och folkhälsovetare, har vi en bred kunskapsbas för det arbetet. Det är väldigt kul och utvecklande att jobba tillsammans med andra professioner.
Hur ser du på
ditt uppdrag inom STHF?
Inom STHF är jag ordförande i Etiska rådet samt ledamot i THUSAB (Tandhygienisternas service och utbildnings AB) och är stolt och glad att få förmånen att arbeta med dessa frågor och uppmanar alla som får en möjlighet
vi mest som bollplank och stöd för medlemmar som har behov av det. Det är alltid den enskilde som besvarar frågor från till exempel IVO, men vi kan hjälpa till och ibland slussa vidare till andra instanser om det finns behov av det.
Inom THUSAB jobbar jag ofta i vår monter på Tandhygienistdagarna och Riksstämman. Det är alltid lika kul att träffa er kollegor och andra inom branschen som övriga professioner, utställare och samarbetspartners.
Vad är viktigast för Sveriges
Tandhygienister just nu?
Att finnas till och vara den aktör och part som tillvaratar tandhygienisters intressen och är remissinstans vid myndighets -
kontakter. Det är genom detta arbete som vi tandhygienister blir lyssnade till och har möjlighet att påverka. Denna roll har byggts upp under lång tid med noggrant arbete. Ibland kanske vi tar den för självklar.
För den enskilde är det naturligtvis viktigt med bra arbetsförhållanden oavsett var man är verksam. Det är också väldigt viktigt att det finns kompetenta människor att fråga till råds när så behövs. Allt detta finns inom STHF:s styrelse och på SRAT:s kansli för oss medlemmar i STHF.
Vilken bakgrund har du?
Jag är utbildad tandsköterska 1982 och sedan till tandhygienist 1991. Från 1992 har jag varit engagerad på något sätt inom föreningen. Första kontakt var genom en kollega som bjöd med mig till STHF:s lokalföreningsmöte i Skaraborg. Där var jag sedan aktiv under många år, både i föreningen och på olika poster inom lokalföreningens styrelse. Det var så givande och lärorikt – jag tipsar alla att ta del av den kunskap och gemenskap som finns i era lokalföreningar.

Vad gör du när du inte jobbar?
Jag gillar verkligen att vara ute i naturen, gärna vandra eller njuta i trädgården. Finns det möjlighet till ett kallbad tar jag gärna det.
Ordförande
Yvonne Nyblom
yvonne.nyblom@tandhygienistforening.se 073-366 63 99




Fouzieh Eliassy
fouzieh.eliassy@tandhygienistforening.se

Ingela Jägestrand
ingela.jagestrand@tandhygienistforening.se 070-144 32 74
Monica Ringdahl
monica.ringdahl@tandhygienistforening.se
Marie Sand marie.sand@tandhygienistforening.se
Ulrika Lindmark
ulrika.lindmark@tandhygienistforening.se

Helen Östholm
helen.ostholm@tandhygienistforening.se
www.tandhygienistforening .se info@tandhygienistforening.se
BLEKINGE
Linda Holtne linda.holtne@regionblekinge.se
BOHUS ÄLVSBORG
Sofia Bertilsson sofia.e.bertilsson@vgregion.se
DALARNA
Ellen Paulfors ellen.paulfors@regiondalarna.se
GOTLAND
Agneta Rahm Nordén agnetharn@gmail.com

GÄVLEBORG
Christin Wahlberg christin.wahlberg@regiongavleborg.se
GÖTEBORG
Patricia Carlsson, 031-43 06 80 gbgtandhyg@gmail.com

HALLAND
Birgitta Kollar birgitta.kollar@regionhalland.se
JÄMTLAND/HÄRJEDALEN
Linda Hallqvist linda.hallqvist@ptj.se
JÖNKÖPING
Sanela Skripac sanela.ee@hotmail.com
KALMAR
Susanne Svensson
susanne.svensson4@regionkalmar.se
KRONOBERG
Ulrika Tegsved Lindroth ulrika.lindroth@outlook.com
NORRBOTTEN
Christina Björling christina.bjorling@norrbotten.se
SKARABORG
Åsa Friberg
asahfriberg@outlook.com
SKÅNE
Lina Gassner Kanters
tandhygienisternaiskane@gmail.com
STOCKHOLM
Drandafile Rrecaj drandafile.rrecaj@smile.se
SÖDERMANLAND
Lisbeth Eriksson lisbeth.eriksson@regionsormland.se
UPPLAND
Annelie Mattsson annelie.mattsson@regionuppsala.se
VÄRMLAND
Anna Filipsson
anna.filipsson@regionvarmland.se
VÄSTERBOTTEN
Emelie Larsson emelie.larsson@regionvasterbotten.se
VÄSTERNORRLAND
Marie Englund englundlindberg@hotmail.se
VÄSTMANLAND
Pia Abrahamsson pia_486@hotmail.com
ÖREBRO
Charlotte Holmgren charlotte_holmgr@hotmail.com
ÖSTERGÖTLAND
Anneli Backman
anneli.backman@regionostergotland.se
STHF:s Nätverk
Nätverk Doktorander
Nätverk Forskarutbildade tandhygienister
Nätverk Kliniska handledare
Nätverk Ledarskap
Nätverk Lokala förhandlare
Nätverk Sjukhustandhygienister
Nätverk Äldre
Kontakt Monica Ringdahl monica.ringdahl @tandhygienistforening.se
STHF:s Chefsråd
STHF:s Chefsråd inom chefsnätverket bidrar bland annat med chefsstöd tandhygienistkollegor emellan.
Ordförande Janna Lindroos janna.lindroos@rjl.se
Ledamot Anna Edvardsson annaedvardsson@hotmail.com
Ledamot Catarina Eldh catarina.eldh@oralcare.se
STHF:s Vetenskapliga råd
STHF:s Vetenskapliga råd har till uppgift att vara sakkunnigt i vetenskapliga frågor.
Ordförande Kajsa H Abrahamsson kajsa.henning.abrahamsson @odontologi.gu.se
Ordförande Carina Thuresson tandhygienistforetagarna@gmail.com
Medlemsfrågor Olga Tagner tandhygienistforetagarna@gmail.com
STHF:s Etiska råd
STHF:s Etiska råd har till uppgift att vara rådgivande till enskilda tandhygienister och egna företagare som är medlemmar i STHF samt till lokalföreningar.
Om du i din yrkesutövning blir anmäld till Inspektionen för vård och omsorg, kan Etiska rådet fungera som stöd och hjälp. Rådet kan också hjälpa till att formulera svar till myndigheten. Etiska rådet har också till uppgift att revidera och hålla de yrkesetiska riktlinjerna aktuella.
Ordförande Christina Prestgaard c.prestgaard@gmail.com
Ledamot Marie Jansson marie.jansson@rlj.se
Ledamot Stina Svensson stina.u.svensson@vgregion.se
Kansli SRAT
Sveriges Tandhygienistförening
Box 1419. Besöksadress: Oxtorgsgatan 9–11
111 84 Stockholm
Tfn: 08-442 44 60
E-post: info@tandhygienistforening.se Förhandlare
Hanna Adlerteg-Melinder
08-442 4468 hanna.adlerteg-melinder@srat.se
Christel Bridal
08-442 4461 christel.bridal@srat.se
Sverker Jutvik 08-442 4475 sverker.jutvik@srat.se
Medlemsservice kansli@srat.se
Kommunikatör STHF
Lena Munck lena.munck@tandhygienistforening.se
STHF:s Valberedning
Anna Magnusson anna.magnusson@rjl.se
www.tandhygienistforening.se info@tandhygienistforening.se
Internationellt: STHF ingår i två internationella tandhygienistorganisationer
International Federation of Dental Hygienist’s


ifdh www.ifdh.org
European Dental Hygienist´s Federation
edhf www.edhf.eu
STHF:s representanter
yvonne nyblom yvonne.nyblom @tandhygienistforening.se fouzieh eliassy fouzieh.eliassy@tandhygienistforening.se
MUNKONTROLL var rätt svar på krysset i nr 6. Bland många
inskickade svar drogs vinnarna
IngMari Isacson, Hässelby och
Annie Reingård, Stensjön. Grattis!

NYA KRYSSET. Gör så här: När du löst korsordet hämtar du in bokstäverna (1–8) till den vågräta blå raden nedan. Skicka in ditt svar senast den 22 mars 2023 kl. 24.00 till
HERRE PÅ TÄPPAN
GÖR RÖRT ÖGA
redaktion@tandhygienistforening.se. Vi drar två vinnare bland de rätta svaren. Vinnarna meddelas via mejl senast 14 april och får 2 biobiljetter var. Lycka till!

FYLLS REGELBUNDET
HEMSIDA
TURIST HEN VISKAR PÅ JOBBET
FRISTAD BOLAG
DRAR KÖKSFLÄKT
ALLTJÄMT PRIS KRÄVER OLJA
LÄTT ED
KOMMA FRAM
SLÄKT FRÄTA PÅ YTAN KORT STRÅLNING LODALEN I HYLLAN VIRUS NORDBO
GIFTIGT DJUR
RÄTTSPROTEST
VIKT ÄPPELSORT
GULD FJÄRDE MANNEN
TUSENDEL SOM FÖRLED
VREDE
VID VAL
KÄRNLÄGE
KEJSARE I ÖSTER SLÅR SAX PASSA SLÅR HIT PART SÄNKA
DRÖJA
PASSÉ GÅNGART
TACKTAL
DELAD
DURKSLAG NÄMNDE
ERBIUM MODERNÄRING
LIGGER DEN TRÄGNE
ÄR KVAR PÅ HYLLAN FÖRR
ODEN
PÅ SPÖ
SPRIT FRID
RÖR DATA KRING NERVCELL
ÄR INTE SOCIALA
FÅTT IHOP
UNGEFÄR SOM VICE KAMP FÖRLÅT
HAR FET TEXT
FÅR KID BOK MED MJUKA PÄRMAR
FÖRST OCH SIST
BARA NÅGRA
© BENSONX BENGT CARLSON
60 % av bakteriell plack kan finnas kvar efter enbart borstning, vilket kan leda till ytterligare tandköttsproblem som kräver effektiva antibakteriella produkter.1
När tandvårdsprodukter smakar obehagligt eller leder till missfärgning, kan det hända att patienter inte följer sin munhygienrutin.

Korttidsanvändning:
PerioGard® klorhexidin (CHX)

0,12 % CHX munskölj
Används i upp till 4 veckor
42 % mindre missfärgning efter 4 veckor *2
Med unikt antifläcksystem
Daglig munvård:
PerioGard® Gum

Protection tandkräm Långvarig antibakteriell effekt *,3-5
Utformad för följsamhet - 8 av 10 personer tycker om smaken från första användningen^6
Till patienter med tandköttsproblem rekommenderar vi PerioGard ® för att uppmuntra till följsamhet och skapa positiva kliniska resultat.

Scanna här för att lära dig mer om NYA PerioGard ® eller gå in på colgateprofessional.se


et al. JADA 2021:152(2):105–114. 6. Data on file. Colgate-Palmolive Company, 2022.


1. Borstning med vanlig fluortandkräm. Chapple I, et al. Clin Periodontol 2015;42(Spec Iss):S71–S76. 2. Vs 0,12% CHX utan antifläcksystem. Fine D, et al. (2019). (CRO-2018-05-CHX-ED). 3. Kontinuerlig användning. Hu D, et al. JADA 2019:150(4 suppl): S32–S37. 4. Vs. Enbart CPC. Rösing CK, et al. Braz. Oral Res. 2017;31:e47. 5. Vs en konkurrents munskölj med eteriska oljor i en alkoholfri bas. Langa GPJ,
Sveriges Tandhygienistförening
Box 1419
111 84 STOCKHOLM
WP-64M Putsvinkelstycke
Puts 4:1 med unik trippeltätning.
Använd Young gummikoppar med W&H putsvinkestycke WP-64M Trippelseal. Denna kombination medför en unik tätning (sitter i varje kopp) mellan kopp och huvud som utestänger blod, saliv och putspasta vilket resulterar i lång livslängd på intrumentet samt bästa hygien.
* Trådlöst putsvinkelstycke
100% HYGIEN = Samtliga gummikoppar på marknaden är engångs 2


W&H Nordic AB, t: 08-445 88 30, office@whnordic.se, wh.com :whnordic
